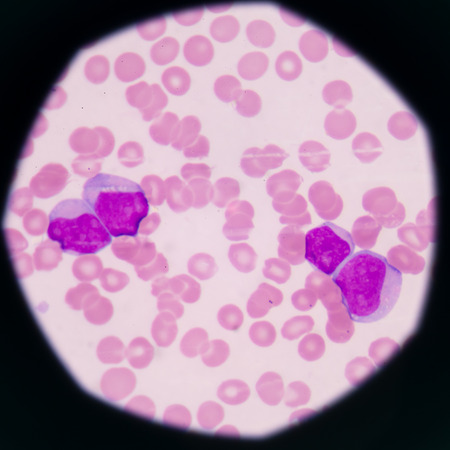
blood smear is often used as a follow-up test to abnormal results on a complete blood count (CBC) to evaluate the different types of blood cells.Medical science background showing blast cells(AML)

Stock photo 1-49472589
Royalty-free photo blood smear is often used as a foll...
- Description: Photo by toeytoey. blood smear is often used as a follow-up test to abnormal results on a complete blood count (CBC) to evaluate the different types of blood cells.Medical science background showing blast cells(AML)
- Id: 1-49472589
- Media type: Photos
- Author: toeytoey
- Keywords:
abnormal acute anemia antigen bactericidal band basophil beta biology blast blood bone cell cytoplasm decrease disease granulation health hematology immune response increase infection laboratory leukemia leukocyte lymphocyte macrocyte marrow medical medicine microbiology microcyte microscope myeloblast myeloblastic myelocyte neutrophil normal nucleus pathology phagocytes platelet response slide smear system thalassemia thalassemias toxic white
More infos
| Size | Width * Height | MB | Price ($) |
|---|---|---|---|
| Web (jpg) | 692 px * 692 px | 1.37 | 3 |
| Print (jpg) | 2048 px * 2048 px | 12 | 6 |
| Extra large (jpg) | 3937 px * 3936 px | 44.33 | 10 |
| TIFF format (tiff) | 4921 px * 4920 px | 69.27 | 12 |
You are not logged in !
Login in order to download this image.
Incredible stock. Flexible pricing. Buy credits and start downloading today.
Please wait, your image is being downloaded
